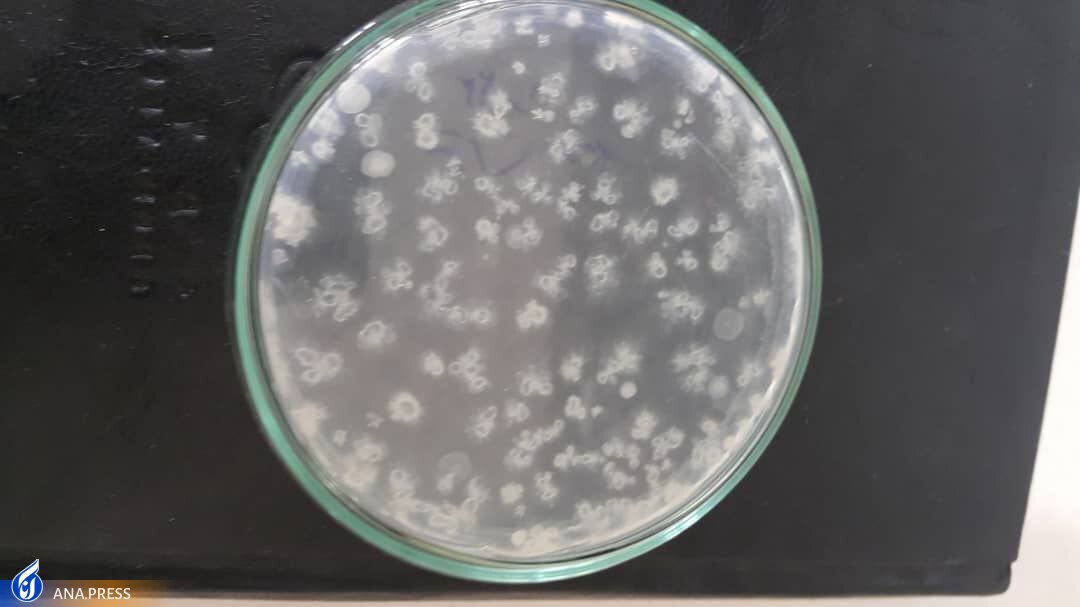
حذف نگهدارنده‌های شیمیایی از صنایع غذایی با فناوری پلاسمای سرد

حذف نگهدارندههای شیمیایی از صنایع غذایی با فناوری پلاسمای سرد
خبرگزاری علم و فناوری آنا؛ احسان عربی مفرد- عرفان شعبانی که تحصیلات مقطع کارشناسی و کارشناسی ارشد خود را در رشته مهندسی شیمی گرایش صنایع غذایی در دانشگاه آزاد اسلامی واحد کرمانشاه طی کرده اکنون دانشجوی ترم آخر دکتری مهندسی صنایع غذایی دانشگاه آزاد اسلامی واحد ورامین - پیشوا و قرچک است. او دارای چند مقاله علمی پژوهشی در ژورنالهای علمی و تخصصی در داخل و خارج ایران بوده و اکنون در زمینه تکنولوژیهای نوظهور مانند پلاسمای سرد و نانوفیلترها فعال بوده و در حال رفع نقص دو اختراع است.
شعبانی سال ۱۳۹۲ شرکت فناور«چشمه و خورشید فارمد» را در راستای تولید و توزیع اقلام تجهیزات پزشکی راهاندازی کرد و با توجه به بازار کار و پیشبرد مصالح شرکت در زمینههای دیگری مانند صنعت آب و فاضلاب و صنعت کشاورزی نیز فعالیتهایی کرد که منجر به بستن چند قرارداد با وزارت نیرو و وزارت جهاد کشاورزی شد.
دانشجوی دکتری مهندسی صنایع غذایی که اکنون علاوه بر تحصیل در مرکز رشد واحدهای فناور دانشگاه آزاد اسلامی واحد ورامین - پیشوا و قرچک هم مستقر و فعال است و با مبانی شرکتهای دانشبنیان با توجه به راهنمایی استادان راهنما، آشنا شده در گفتوگو با خبرنگار خبرگزاری علم و فناوری آنا در تشریح فعالیتهای فناورانه و دانشبنیان شرکت متبوعش و حیطه فعالیت آن اظهار کرد: پیرو منویات مقام معظم رهبری مبنی بر تولید دانشبنیان به فعالیتهای دانشبنیان و قراردادن شرکت در مسیر دانشبنیانشدن با عضویت در مرکز رشد پژوهشگاه مرجع شیمی و مهندسی شیمی ایران اقدام کردیم.

** فعالیت فناوران در زمینه تکنولوژی نوین پلاسمای سرد
وی با بیان اینکه در مراحل بعدی به مراحل دانشبنیان شدن شرکت اقدام شد، اضافه کرد: اکنون شرکت در زمینه تکنولوژی نوین پلاسمای سرد فعالیت میکند که منجر به تولید چند محصول ازجمله دستگاه تولید آب تصفیه شده توسط پلاسمای سرد و جایگزینی پلاسمای سرد به جای فناوریهای گذشته مانند فناوریهای شیمیایی گندزدایی، کلرزنی و.. شده است.
عضو باشگاه پژوهشگران جوان و نخبگان دانشگاه آزاد اسلامی واحد ورامین - پیشوا ادامه داد: در صنعت نگهداری مواد غذایی نیز به ساخت چند محصل از پلاسمای سرد به منظور استریلزاسیون و پاستوریزاسیون غیرحرارتی برای افزایش ماندگاری محصولات حساس کشاورزی اقدام کردیم که منجر به افزایش مدت نگهداری به منظور امکان صادرات محصولاتی مانند میوه و سبزی با توجه به رویکرد صادراتمحور کشور شده است.
** طراحی و ساخت چند محصول استراتژیک در حوزه صنعت
این فعال حوزه فناوری در پاسخ به این پرسش که از چه زمانی فعالیت خود را آغاز کردید و تاکنون چه موفقیتهایی در مسیر طی شده حاصل شده است و چه دستاوردهایی داشتهاید؟ گفت: فعالیتهای ابتدایی شرکت از سال ۱۳۹۲ صورت گرفت؛ اما در مسیر محصولات و طرحهای دانشبنیان از سال ۱۳۹۹ برای جمعآوری اطلاعات و اقدامات اداری اقدام کردیم تا در مسیر دانشبنیان قرارگرفتن آغاز شد و اکنون با همت همکاران و فعالیتهای شبانهروزی، موفق به طراحی و ساخت چند محصول استراتژیک شدهایم که در رایزنیهای صورت گرفته با چند وزارتخانه در شرف عقد دو قرارداد راهبردی در صنایع کشور هستیم.
فقط با حمایتهای معنوی و ایجاد تسهیلات میتوان کارهای بزرگی در راستای پیشبرد مصالح کشور انجام داد.
وی درباره کسب درآمدهای غیرشهریهای دانشگاه از طریق شرکت دانشبنیان بیان کرد: با توجه به اینکه شرکت در آستانه عقد دو قرارداد مهم و استراتژیک در سطح ملی است، امیدواریم بتوانیم سهمی از کسب درآمد غیرشهریهای را برای دانشگاه آزاد داشته باشیم؛ چراکه استادان راهنما دارای سهم بزرگی در راهنمایی به منظور قرارگیری فناوران در مسیر کسب و کار بودهاند و قطعاً سهم بزرگی از فعالیتهای شرکت، نتیجه ساخت بستر مناسب در دانشگاه آزاد بوده است.
** کاهش هزینههای تولید محصولاتی مانند آب شرب و بستهبندیهای مواد غذایی
دانشجوی دکتری مهندسی صنایع غذایی درباره اینکه محصولات فناور شرکت چه نیازی از نیازهای مردم و کشور را برطرف میکند، توضیح داد: فناوری پلاسمای سرد از فناوریهای نوظهور در دنیا بوده و از زیرمجموعههای فناوری هستهای ایران محسوب میشود. با توجه به اینکه استفاده از محصولات شیمیایی نگهدارنده و یا مبارزه با فساد در صنایع مختلف مانند صنعت آب و فاضلاب و صنایع غذایی همواره در محور سلامت مورد چالش بوده است، فناوری ساخته شده توسط متخصصان مستقر در شرکت دانشبنیان چشمه خورشید فارمد میتواند تا حدود زیادی نگهدارندههای شیمیایی را حذف کرده و هزینههای تولید محصولاتی مانند آب شرب و بستهبندیهای مواد غذایی را به میزان قابل توجهی کاهش دهد که در این راستا محصولی سالمتر و دارای کیفیت بالاتر و هزینه تمام شده کمتر به هموطنان ارائه میشود.
شعبانی در تشریح نواقص و کمبودهای مسیر تجاریسازی محصولات فناور بیان کرد: بزرگترین نقص و کمبود در راه تجاریسازی محصولات فناور، وجود بروکراسی پیچیده اداری کشور است که معتقدم وجود مشاوران حقوقی حمایتگر از شرکتهای دانشبنیان میتواند کمک خوبی به شرکتهای دانشبنیان کند.
** بازار هدف فروش محصولات فناور، نیازمند تبلیغات گسترده و فرهنگسازی
این فعال دانشبنیانی تشریح کرد: جدا از بروکراسی اداری موجود در برندسازی و...، ساخت بازار هدف برای فروش محصولات فناور، نیازمند همت والا برای ارائه به بازار و تبلیغات گسترده و فرهنگسازی است که حمایتهای معنوی دولت، صدا سیما و دانشگاه میتواند راهگشا باشد و جدا از اینکه به اقتصاد کشور توان کمک دارد، میتواند منجر به اشتغال پایدار شود.
وی اضافه کرد: ساخت گروههای همیاریکننده با حضور کارشناسان فنبازار و طراح در زمینه فعالیتهای اینترنتی شرکتهای نوپا، میتواند تأثیر بسیار گستردهای در تولید محصولات تجاری دانشبنیان داشته باشد و بازار کشور و کشورهای همسایه را دربرگیرد، این مهم، مستلزم تشکیل کارگروه در نهادها و وزارتخانههای مختلف و حمایتهای دولت و نیازمند تلاشی انقلابی در صنعت بوده است که مقام معظم رهبری همواره بر آن تأکید دارند.

مدیرعامل این شرکت دانشبنیان با بیان اینکه از لحاظ مالی، حقوقی و تبلیغی هیچگونه حمایتی از شرکت توسط مسئولان صورت نگرفته است، انتظار فعالان عرصه دانشبنیان را حمایت و اعتماد به قشر جوان و تحصیلکرده دانست و گفت: فقط با حمایتهای معنوی و ایجاد تسهیلات میتوان کارهای بزرگی در راستای پیشبرد مصالح کشور انجام داد.
عضو باشگاه پژوهشگران جوان و نخبگان دانشگاه آزاد اسلامی واحد ورامین - پیشوا یادآور شد: در بحران کرونا آسیبهایی به اقتصاد شرکت مانند بسیاری از شرکتهای مختلف وارد شد که بعد از گذراندن شوک اولیه ناشی از کرونا به منظور حفظ حیات شرکت به تولید ماسکهای یکبار مصرف طبی اقدام کردیم.

انتهای پیام/


